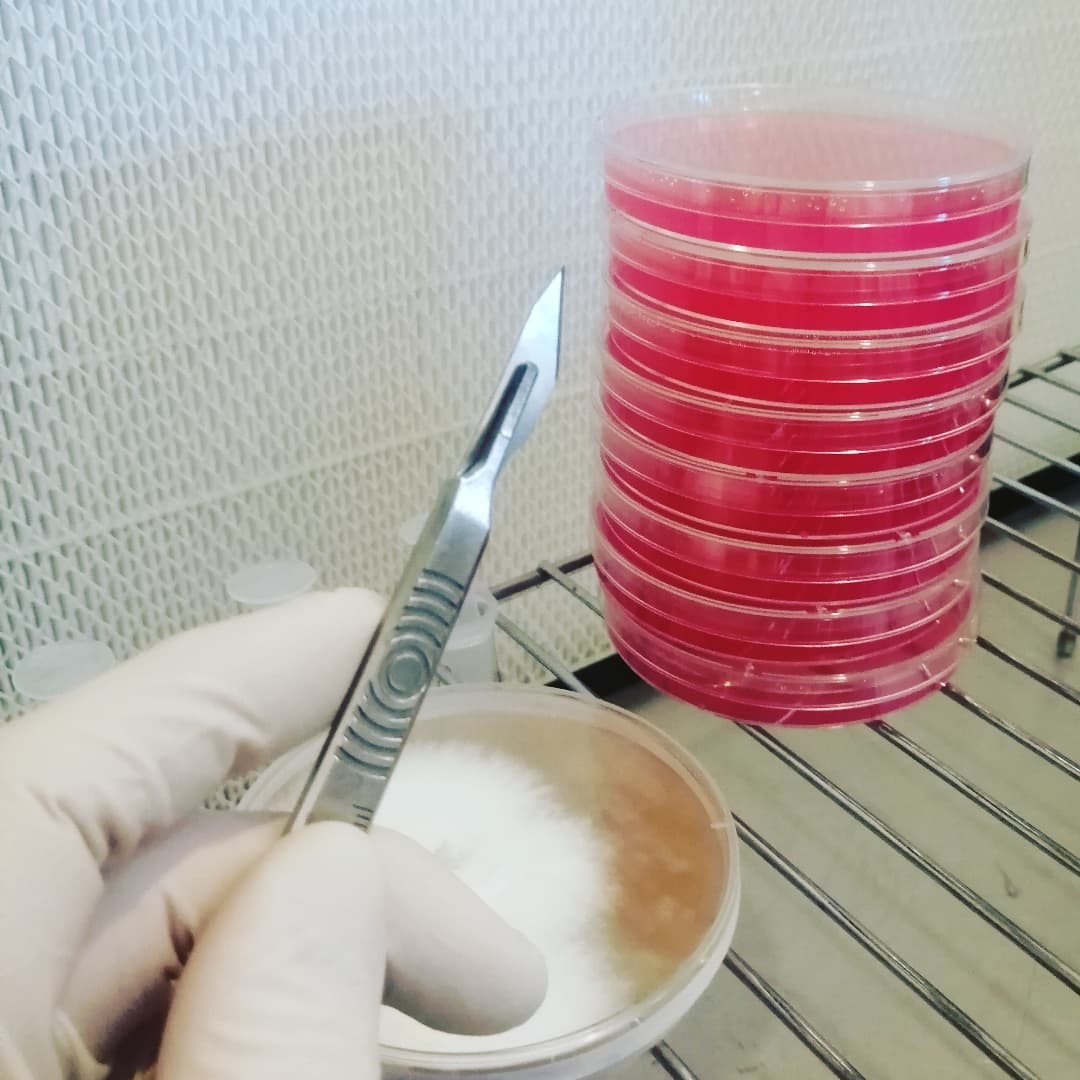
Ganoderma applanatum, Artists bracket wild clone onto ampicillin plates. #mycology #mycelium #wildclone #polypore #bracket #fungus #fungi #antibiotic #ampicillin #agar #myceliumrunning #mushroomcultivation #mushroomgrowing #mushroomfarm #mushlove

top of page
SHIPPING AVAILABLE TO MOST OF EUROPE
ABOUT FUNGURU FARM
Our mushroom story kicked off in the woods, training our Spaniel to sniff out English black truffles. While the dog was hunting treasure, we found ours and there's no going back.
We’re a family-run operation growing serious mycelium and building products for people who’d rather grow their own than buy. We supply commercial cultivators, small-scale rebels, and a rapidly multiplying army of hobby growers with everything they need.
Grow boldly. Break things (cleanly). Learn fast.
And if you hit a snag, we’ve got your back.


About
Contact

bottom of page